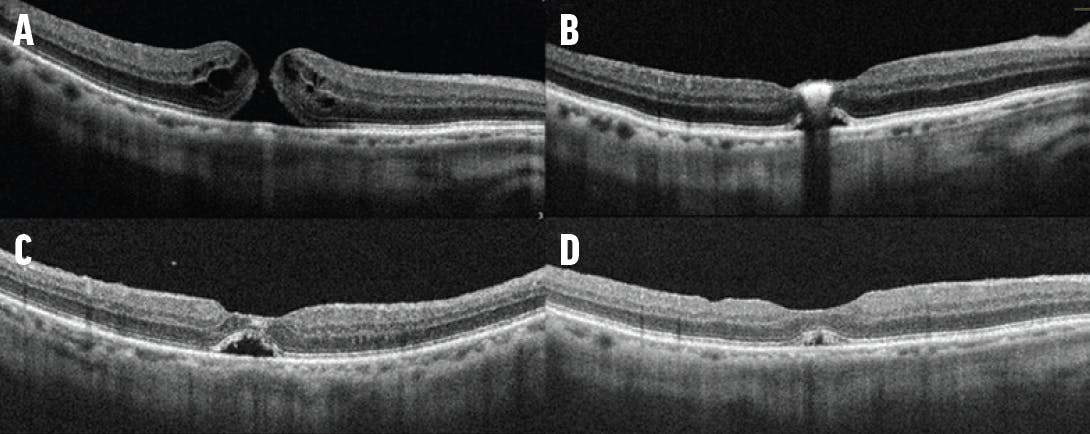

AT A GLANCE
- Surgeons have several intraoperative staining agents to choose from, including indocyanine green (ICG), triamcinolone acetonide, brilliant blue G, and trypan blue.
- Although ICG is widely used, many in vitro studies have shown a dose- and time-dependent cytotoxic effect on the retinal pigment epithelium.
- Patients with residual triamcinolone acetonide on the fovea may often remain symptomatic with a subsequent scotoma in the immediate postoperative period.
The use of staining agents during vitreoretinal surgery, termed chromovitrectomy, can help surgeons visualize structures such as the internal limiting membrane (ILM) in full-thickness macular hole (FTMH) repair or the epiretinal membrane (ERM) while peeling. In addition to macular surgery, intraoperative staining agents can also be used to stain the posterior hyaloid to ensure the presence of a posterior vitreous detachment (PVD) or to visualize membranes in proliferative vitreoretinopathy.1,2
Here, I describe the characteristics of commonly used staining agents in macular surgery (Video), as well as a case of residual postoperative outer retinal triamcinolone acetonide particles in a patient who underwent uncomplicated MH surgery.
DYE CHOICES
Indocyanine green (ICG) is a commercially available dye that comes in a powder form in a single vial of 25 mg lyophilized agent. Each vial is diluted with 10 mL of diluent fluid that accompanies the product to achieve a final concentration of 2.5 mg/mL. Some surgeons add an agent with a higher specific gravity, such as dextrose 5% in sterile water (D5W) or viscoelastic material, to allow for better staining of the ILM. To prepare ICG mixed with D5W, add 0.4 mL of D5W to the reconstituted ICG vial and gently swirl for a final ratio of 1:24 dextrose to ICG.
To prepare an ICG mixture with viscoelastic material, inject 0.5 mL balanced salt solution through the tip of the viscoelastic device syringe to prevent air bubbles when injecting the agent. Then, attach the tip of the 1 mL ICG dye syringe, which should contain an equal volume to the viscoelastic material, to the tip of the viscoelastic syringe. Moving the plunger with both hands in a back-and-forth motion, mix the two agents and transfer to one syringe.
ICG stains the ILM quite well and can also be used to visualize the ERM via “negative staining.” Although this dye is widely used in North America and in other parts of the world, many in vitro studies have shown a dose- and time-dependent cytotoxic effect on the retinal pigment epithelium (RPE), and the clinical toxicity profile of ICG remains controversial.1,3,4 Minimizing the duration of exposure to ICG (ideally less than 30 seconds), removing all residual dye from the vitreous cavity, and diluting the dye with D5W or viscoelastic can help minimize the risk of toxicity. Similarly, some evidence suggests an increased risk of phototoxic effects with endoillumination with ICG.2-4 Minimizing direct foveal endoillumination can help mitigate the risk of long-term RPE damage.
Triamcinolone acetonide (TA) is a preservative-free steroid commonly used to stain the vitreous when inducing a PVD. Many surgeons also use TA to stain the ILM and/or ERM. TA 40 mg/mL can be used alone or diluted 1:4 in balanced salt solution. There is no known evidence of direct toxicity with this agent.
To use TA as a staining agent during macular surgery, first remove the steroid that was injected for PVD induction and reinject the product using a small amount to create a several microns-thin layer of stain. This technique allows for optimal visualization of the retina under the stain and avoids inadvertent deep grabs or vascular nicking. The 27- or 30-gauge needle should be changed between each injection, as the emulsified product can clog the needle tip quickly. The assistant or scrub nurse should also be instructed to agitate the syringe well, and only prime the product seconds before injection.
Following ILM or ERM peel, remove all residual TA particulates from the vitreous. Although this product is safe, there is a hypothetical risk of postoperative sterile endophthalmitis, and residual steroid may delay MH closure.
Brilliant blue G (BBG) is a commercially available dye at a 0.025% concentration that is FDA-approved to stain the ILM. Although not as efficacious as ICG, BBG is considered safer with reduced risks of cytotoxic damage to the RPE. Like ICG, BBG can also be mixed with D5W. Several authors have suggested better final visual acuity with the use of BBG over other macular staining agents, with no added advantage in rates of MH closure.5,6
Trypan blue is another commercially available dye at a 0.15% concentration and is commonly used in anterior segment surgery to stain the lens capsule. This dye can also be used to stain the ILM in MH surgery, as well as the ERM in proliferative vitreoretinopathy or diabetic membranes.
CASE EXAMPLE
A 67-year-old man presented with a 3-month history of right eye distortion and blurry vision with baseline VA of 20/70 OD. He was phakic with 1+ nuclear sclerotic cataract and no past ocular or medical history. His OCT demonstrated a small FTMH in the right eye (Figure 1A), and he underwent uncomplicated combined phacovitrectomy in the right eye 1 month later. In this case, intravitreal TA was used to stain the posterior hyaloid, which was tightly adherent to the optic nerve and macula. Following PVD induction, a few residual triamcinolone crystals were noted. BBG was used to stain the ILM, which was peeled circumferentially without any complications. Following a complete fluid-air exchange, the eye was flushed with 20% SF6 gas. The patient was instructed to assume a face-down position for 5 to 7 days while awake.
Figure 1. A preoperative OCT of the patient’s right eye demonstrating a small FTMH (A). At 1 week postoperative, the OCT showed an intensely bright outer retinal hyperreflective lesion corresponding to TA particles on the fovea (B). The TA particle is smaller on OCT at week 3 postoperative with residual subretinal fluid (C). At month 2 postoperative, the TA residue is fully absorbed and the subretinal fluid is reduced significantly (D).
At postoperative week 1, the gas fill was 40%, and a small but highly reflective TA crystal was seen clinically and on OCT (Figure 1B). At 3 weeks postoperative, the patient noted a small central scotoma in the right eye, and the crystal particle was still visible as a hyperreflective outer retinal lesion on OCT imaging with a small amount of residual subretinal fluid (Figure 1C).
By 2 months postoperative, the TA residue had absorbed, but a small residual amount of subretinal fluid remained (Figure 1D). This patient’s final VA improved to 20/30+1, and he no longer noted a scotoma in the right eye. Fundus autofluorescence did not show any evidence of RPE changes in the macula at 2 months follow-up.
DISCUSSION
TA is one of the most commonly used agents in vitreoretinal surgery.7 Despite its high safety profile, some case reports have noted TA crystals that have delayed or interfered with MH closure.8,9 More recently, authors have reported larger case series and cohort studies with excellent anatomical and visual outcomes despite residual macular TA crystals.7,10-12 Payne et al reported six cases of stage 3 and 4 FTMH in which residual TA crystals were seen inside the hole, touching the RPE, with no effect on MH closure or final visual acuity.9 In our case, the TA crystal was on the outer surface of the retina and disappeared by 2 months, similar to the timeline reported by others.7,10-12
Although residual TA on the fovea is generally a benign postoperative finding, it is notable that patients may remain symptomatic with a subsequent scotoma in the immediate postoperative period. Our patient also developed persistent subretinal fluid postoperatively, which has been commonly noted in cases of small FTMH, with a longer time to recovery.13,14 It is unclear whether the use of triamcinolone delays the absorption of postoperative subretinal fluid.
Retina surgeons benefit from an array of safe and efficacious staining agents in vitreoretinal surgery. Ultimately, the use of each staining agent for chromovitrectomy depends on factors such as agent availability and cost and surgeon preference.
1. Rodrigues EB, Meyer CH. Meta-analysis of chromovitrectomy with indocyanine green in macular hole surgery. Ophthalmologica. 2008;222(2):123-129.
2. Chromovitrectomy/ILM stain. ASRS Retina Atlas. Accessed November 27, 2022. atlas.asrs.org/article/chromovitrectomyilm-stain-84
3. Rodrigues EB, Meyer CH, Mennel S, Farah ME. Mechanisms of intravitreal toxicity of indocyanine green dye: implications for chromovitrectomy. Retina. 2007;27(7):958-970.
4. Gandorfer A, Haritoglou C, Kampik A. Toxicity of indocyanine green in vitreoretinal surgery. Dev Ophthalmol. 2008;42:69-81.
5. Azuma K, Noda Y, Hirasawa K, Ueta T. Brilliant blue G-assisted internal limiting membrane peeling for macular hole. Retina. 2016;36(5):851-858.
6. Jindal A, Pathengay A, Mithal K, Chhablani J, Pappura RR, Flynn HW. Macular toxicity following brilliant blue G-assisted macular hole surgery - a report of three cases. Nepal J Ophthalmol. 2014;6(11):98-101.
7. Wallsh J, Asahi MG, Gallemore R. Long-term outcomes of macular hole repair with triamcinolone acetonide visualization. Clin Ophthalmol. 2021;15:1607-1619.
8. Yamauchi Y, Nakamura H, Hayakawa K, Sawaguchi S. Persistence of triamcinolone acetonide following macular hole surgery. Acta Ophthalmologica Scandinavica. 2006;84(5):711-712.
9. Yeung CK, Chan KP, Chiang SWY, Pang CP, Lam DSC. The toxic and stress responses of cultured human retinal pigment epithelium (ARPE19) and human glial cells (SVG) in the presence of triamcinolone. Invest Ophthalmol Vis Sci. 2003;44(12):5293-5300.
10. Hikichi T, Furukawa Y, Ohtsuka H, et al. Improvement of visual acuity one-year after vitreous surgery in eyes with residual triamcinolone acetonide at the macular hole. Am J Ophthalmol. 2008;145(2):267-272.
11. Payne JF, Bergstrom C, Yan J, Aaberg Sr TM, Srivastava SK. Residual triamcinolone acetonide sequestered in the fovea after macular hole repair. Retina. 2011;31(1):148-153.
12. Kumar A, Sinha S, Gupta A. Residual triamcinolone acetonide at macular hole after vitreous surgery. Indian J Ophthalmol. 2010;58(3):232-234.
13. Tranos PG, Stavrakas P, Vakalis AN, Asteriadis S, Lokovitis E, Konstas AGP. Persistent subretinal fluid after successful full-thickness macular hole surgery: prognostic factors, morphological features and implications on functional recovery. Adv Ther. 2015;32(7):705-714.
14. Mehta N, Bhardwaj S, Tsui E, Tseng J, Wald K. Residual sub-retinal fluid after idiopathic macular hole repair surgery is not visually significant and resolves within 6 months. Invest Ophthalmol Vis Sci. 2016;57:1090.




_1674488812.jpg?auto=compress,format&w=70)

-1_1674489004.jpg?auto=compress,format&w=70)


















